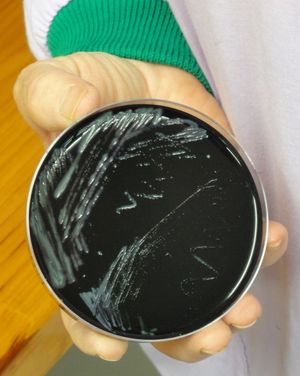
Cultured legionella bacteria on black media

Legionnaires’ disease is a potentially fatal type of pneumonia caused by a strain of bacteria known as legionella. It is not airborne and cannot be transmitted from person to person. While Legionnaires’ disease is commonly thought of as being associated with water, such as in cooling towers, most cases in New Zealand are contracted from gardening activities.
Legionnaires’ disease is a potentially fatal type of pneumonia caused by a strain of bacteria known as legionella. It is not airborne and cannot be transmitted from person to person. While Legionnaires’ disease is commonly thought of as being associated with water, such as in cooling towers, most cases in New Zealand are contracted from gardening activities.
Legionnaires’ disease presents like pneumonia, and while different antibiotics are used to treat the disease, it is not possible to determine what a patient has simply by looking at X-rays. The traditional way to determine if a patient has Legionnaires’ disease is to culture bacteria from sputum (left), but more recently PCR (polymerase chain reaction) tests are also commonly used. Since PCR tests detect DNA, they can determine the presence of legionella bacteria at far lower quantities than culture alone.
A collaboration between Canterbury Health Laboratories, the clinicians at Christchurch Hospital, and the University of Otago, Christchurch, has meant that every person admitted to the hospital with pneumonia is now also routinely screened for Legionnaires’ disease. This novel approach to testing has resulted in a fourfold increase in confirmed cases of the disease when the two years prior to testing are compared with the two years once testing started. The next step is to try and determine what specific activities may be causing the contraction of the disease, by questioning patients as well as those in the general population, as well as rolling this type of testing out to other parts of the country. Ruth Beran speaks with clinical microbiologist David Murdoch and infectious disease clinician Stephen Chambers from the University of Otago, Christchurch to find out why the right diagnosis is so important, and Ros Podmore from Canterbury Health Laboratories shows her what legionella looks like under the microscope.

